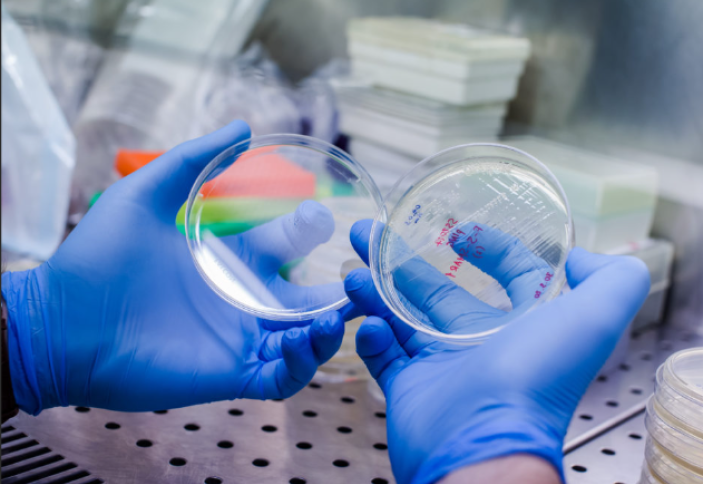
Дәрі-дәрмекке бой бермейтін инфекциялық аурулар көбейіп келеді

|
Дәрі-дәрмекке бой бермейтін инфекциялық аурулар көбейіп келеді
|
Дүниежүзілік денсаулық сақтау ұйымының соңғы есебінде айтылғандай, 2023 жылы әрбір алтыншы бактериялық инфекция антибиотикпен емдеуге келмейтін деңгейде дәрі-дәрмекке төзімділігін қалыптастырып үлгерген. Бұл жайында islam.kz порталы The Guardian мерзімді басылымына сілтеме жасай отырып мәлім етеді. Сарапшылар антибиотикке төзімді инфекциялық індеттер жаһандық денсаулық сақтау саласына үлкен қауіп төндіріп тұрғанын айтып, дабыл қағуда. 2028-2023 жылдар аралығында зәр айдайтын жолдарды, қанды, ішекті және жыныстық жолмен жұғатын инфекциялық ауруларды емдеуде қолданылатын антибтотиктердің 40 пайыздан астамы өзінің тиімділігін жоғалтқан. Әсіресе, бұл тараптағы зерттеу әлемнің 104 елінен 23 млн-нан аса адамның денсаулығына қатысты деректерін қамтыған. Микробқа қарсы дәрі-дәрмеке төзімділігін қалыптастырған бактерияларды, вирустарды, саңырауқұлақтар мен паразиттерді қоса алғанда түрлі індет эволюцияға ұшырайтындықтан антибиотиктердің кейбіреуі уақыт өте келе өз тиімділігін жоғалтады. Тек 2021 жылдың өзінде бактериялық инфекциялардан 7,7 миллион адам қайтыс болды. Бұл ретте дәрі-дәрмекке бактериялардың төзімділігін қалыптастыруынан өлім-жітімнің жартысынан астамы орын алған және 1 миллионнан астамы тікелей инфекциялық індеттен көз жұмған. 2050 жылға қарай антибиотикке төзімді инфекциялық дерттерден жыл сайын 10 миллион адам қайтыс болады.













